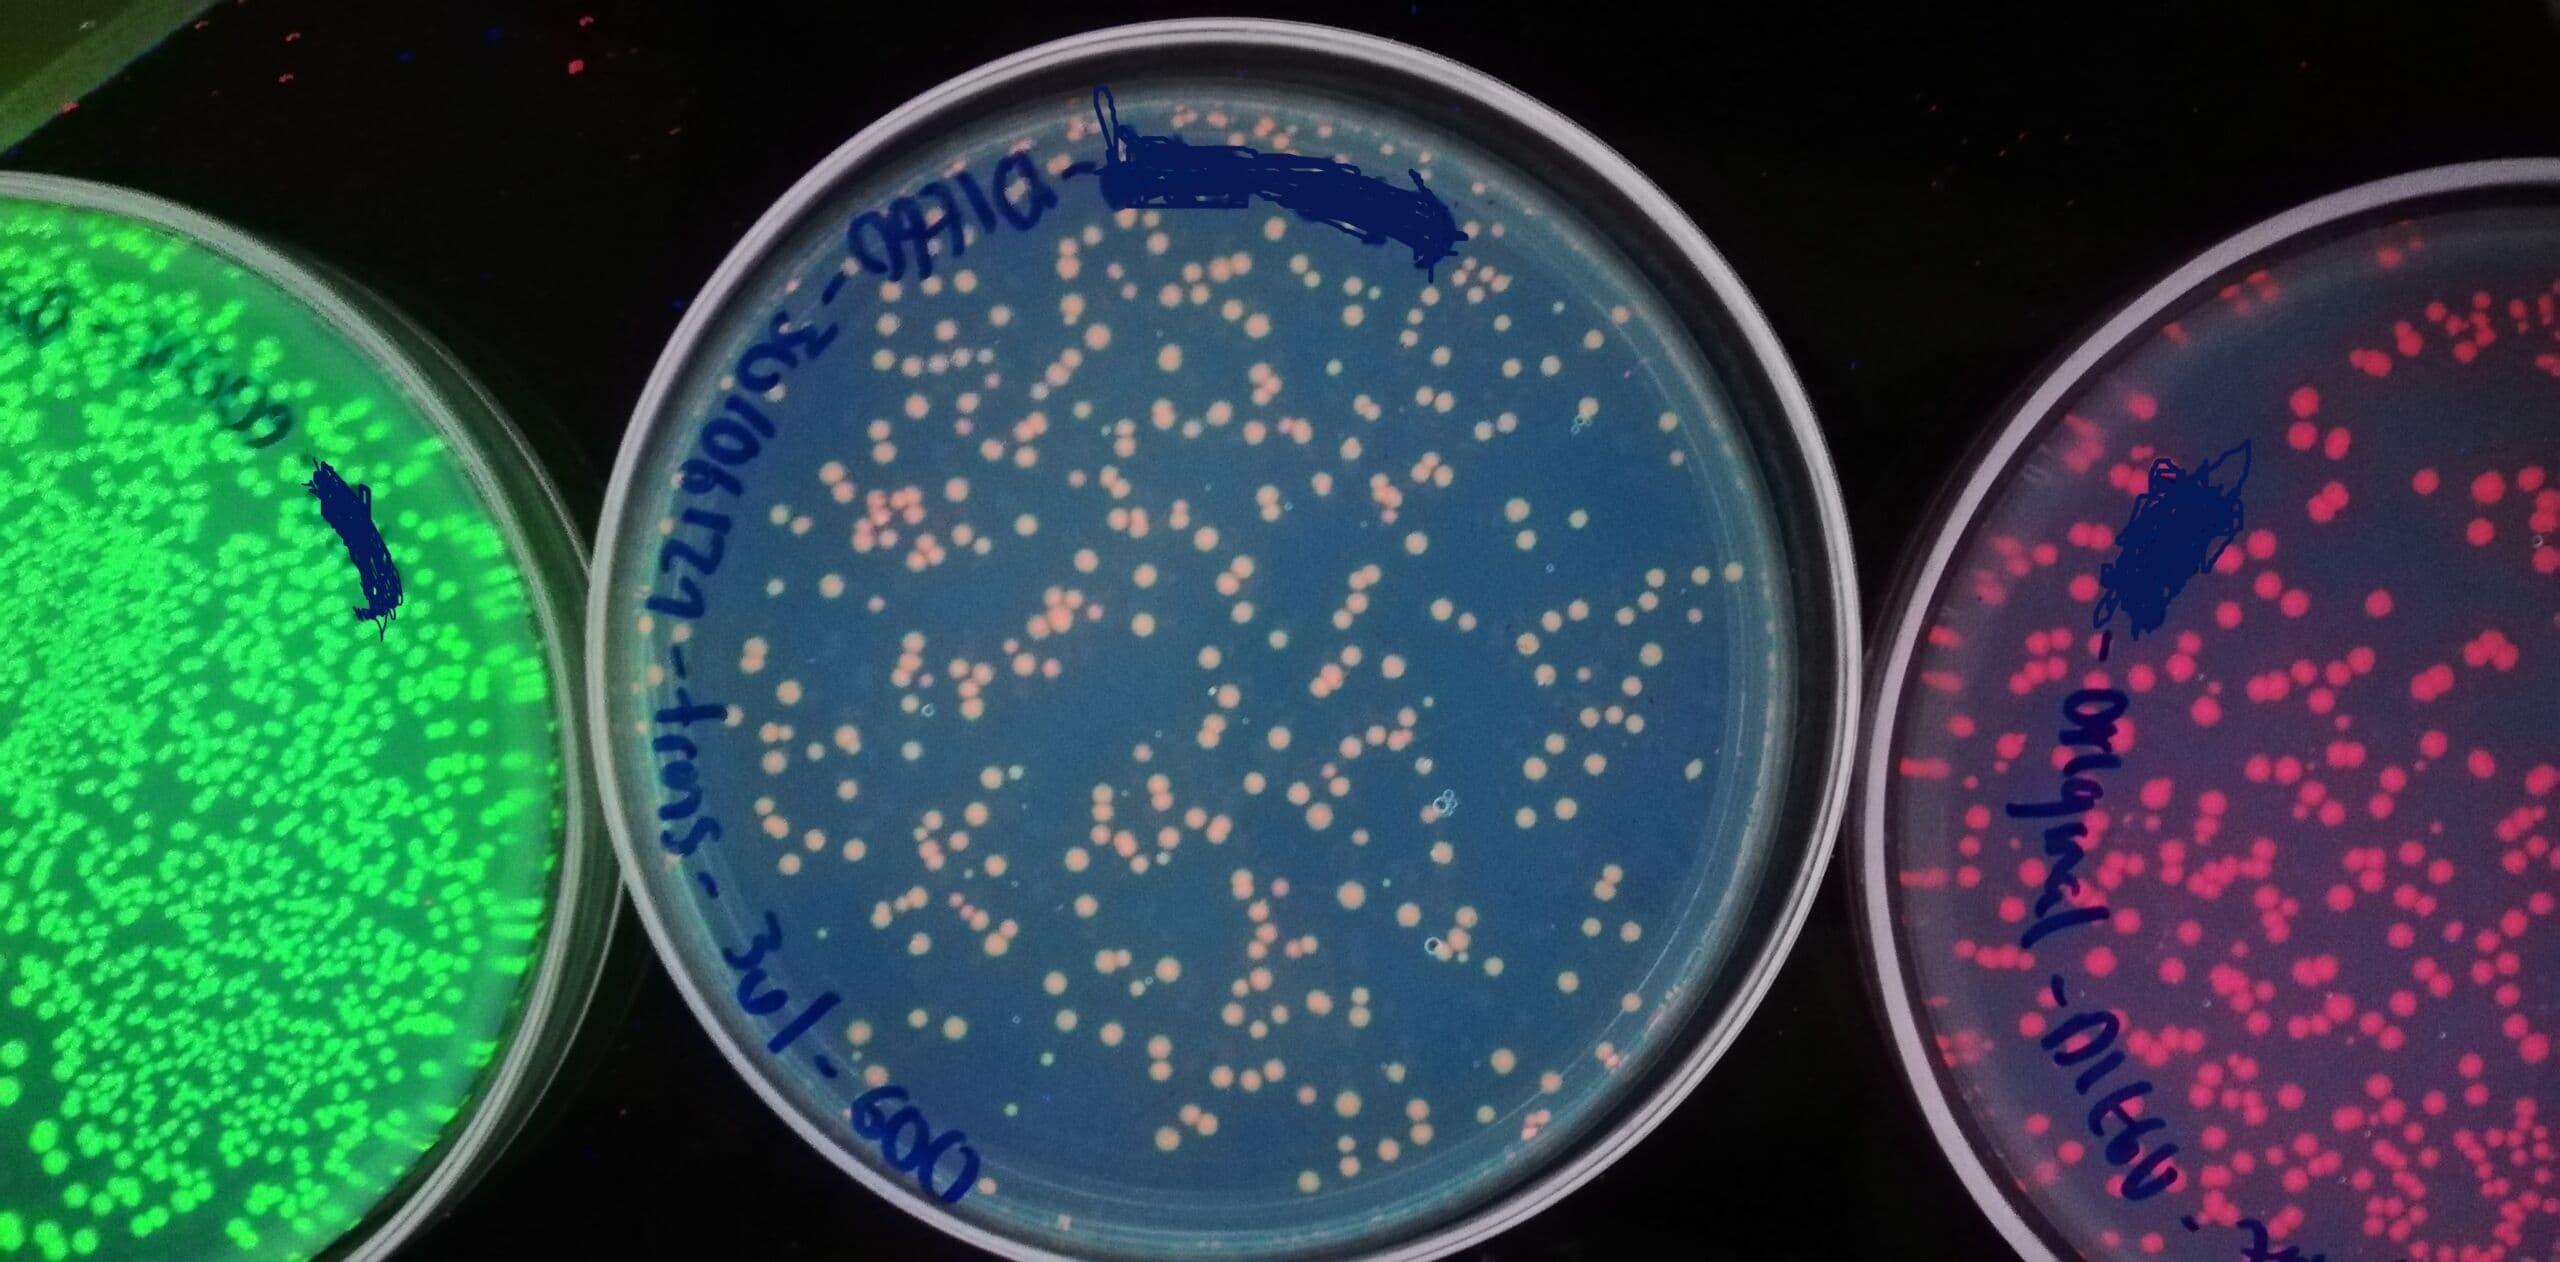
Gallery Image 7
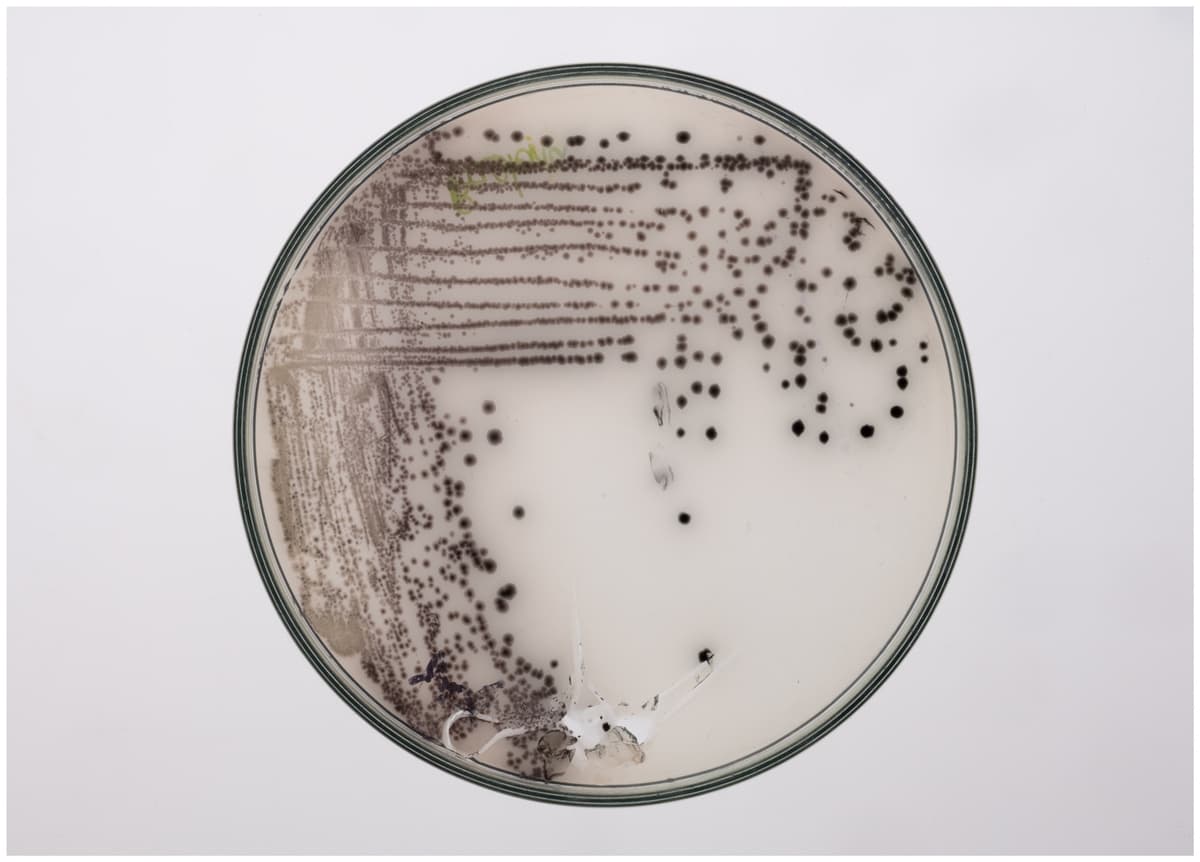
Gallery Image 2
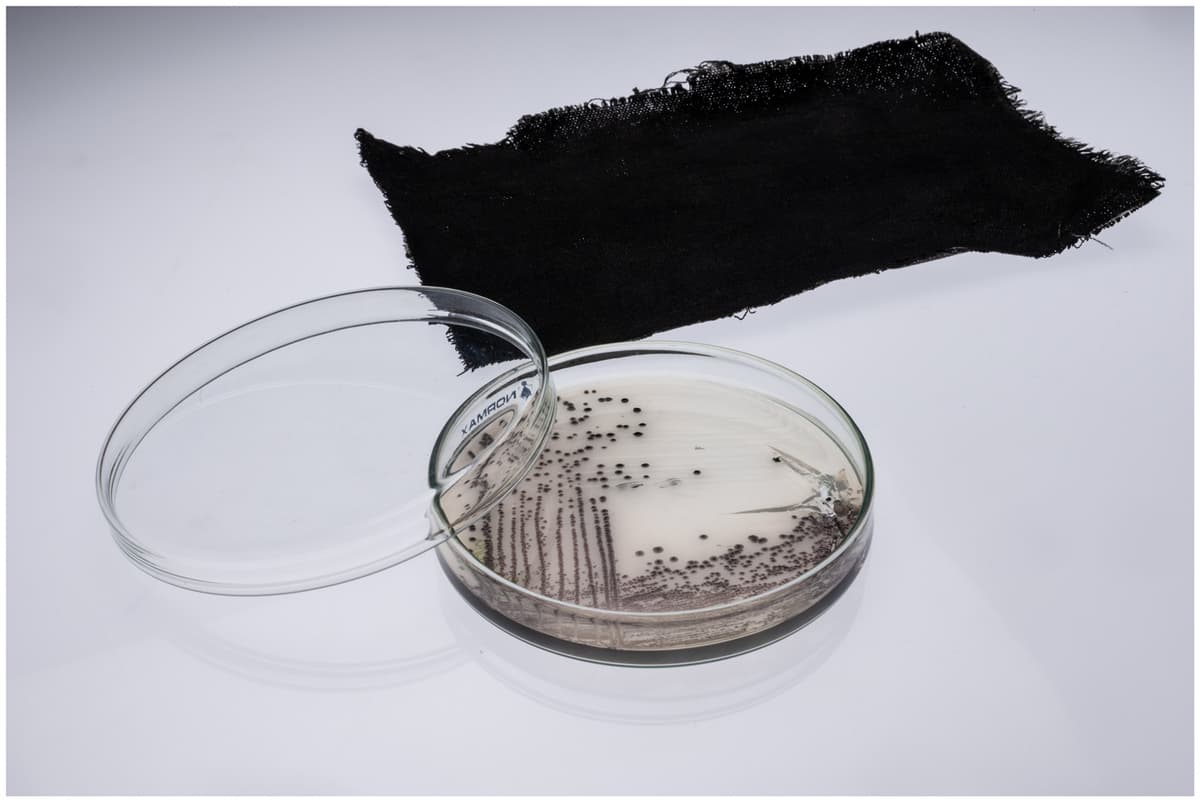
Gallery Image 3
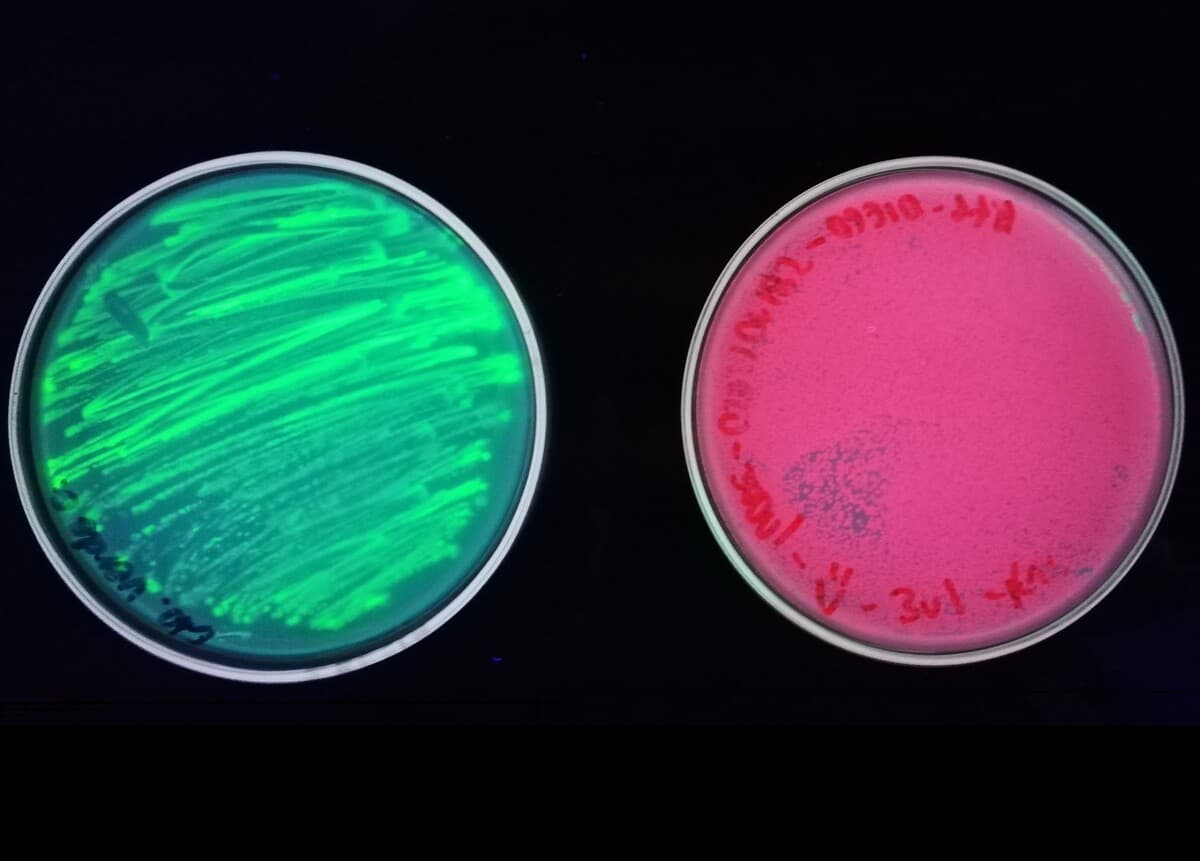
Gallery Image 12

E.biodye

Project Overview
Category
Disciplines
University
Year
About
E.biodye addresses the environmental damage caused by chemical dyes in the textile industry, which is responsible for 20% of global water pollution. The solution involves using engineered bacteria to produce bio-based, biodegradable dyes as a sustainable alternative to traditional petroleum-based dyes. These natural dyes eliminate harmful chemicals, reduce greenhouse gas emissions by operating at lower temperatures, and incorporate water recycling to minimize consumption. This eco-friendly approach significantly reduces the industry’s environmental impact while protecting communities from water contamination
Team
Gallery